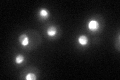
YBR142W

View description
Essential nucleolar protein, putative DEAD-box RNA helicase required for maintenance of M1 dsRNA virus; involved in biogenesis of large (60S) ribosomal subunits
Localization:
Intensity:
Fold change:
Significance:
-
C’ GFP library in SD
nucleus54.81 -
N' NOP1pr-GFP in SD

nucleus,nucleolus0 -
N' TEF2pr-mCherry in SD

nucleus,nucleolus142.529 -
N' NATIVEpr-GFP in SD

nucleus,nucleolus37.8255 -
N' TEF2pr-VC and Cyto-VN in SD

nucleus,nucleolus51.8234 -
C’ GFP library in SD+DTT

nucleus43.980.8No -
C’ GFP library in SD+H2O2

nucleus46.170.84No -
C’ GFP library in Starvation Media

punctateN/AN/AYes -
C’ GFP library on the background of Pup2-DaMP

nucleus -
C’ GFP library on the background of CCT mutant

nucleus53.17180.969987No
